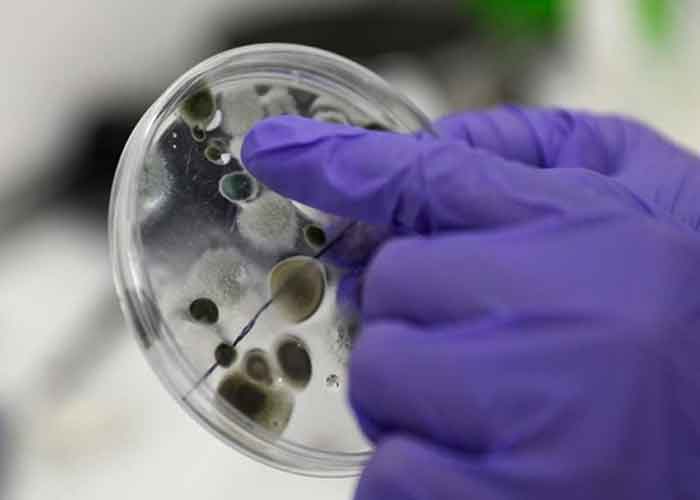

Una nueva mutación del coronavirus, presuntamente procedente de Sudáfrica, ha sido detectada en el Reino Unido, donde se han registrado dos casos de la nueva mutación, según ha afirmado el secretario de Sanidad británico, Matt Hancock.
"Hemos detectado dos casos de una variante más del coronavirus en el Reino Unido", dijo el titular en una rueda de prensa.
Te puede interesar: Llegan a México las primeras vacunas de Pfizer contra la covid-19
Según él, ambos casos son contactos de infectados que viajaron desde Sudáfrica en las últimas semanas.
Transmisible
"La nueva variante es muy alarmante porque es aún más transmisible y parece haber mutado más que la variante [recientemente] descubierta en el Reino Unido", señaló Hancock.
El secretario insistió en que cualquier persona que haya visitado Sudáfrica en las últimas dos semanas se aísle junto con sus contactos íntimos. Se preparan también restricciones sobre los viajes al Reino Unido desde el país africano.
La situación en el Reino Unido continúa siendo preocupante, después de que este martes el país alcanzara su pico de contagios de covid-19 en un solo día, con 36.804 casos y 691 muertes.
También puedes ver: Panamá instala hospitales de campaña ante ascenso vertiginoso de COVID
Con anterioridad, las autoridades británicas informaron sobre la detección de una nueva cepa de coronavirus el 14 de diciembre. Según el primer ministro del Reino Unido, esa variante puede ser "hasta un 70 % más transmisible" que la original.
Por temores a una mayor propagación, las autoridades de varias decenas de países del mundo han suspendido el tráfico aéreo con la nación europea e implementaron pruebas PCR para los pasajeros que han realizado escalas en uno de sus aeropuertos, entre otras restricciones.